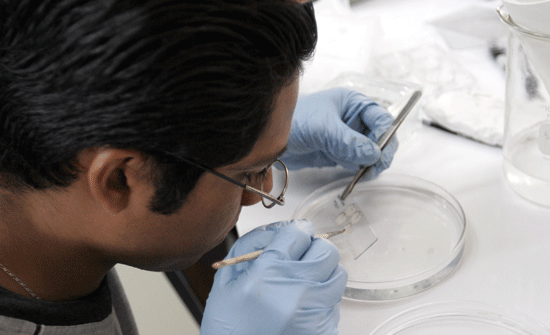

| Año 7 • No. 272 • Junio 25 de 2007 | Xalapa • Veracruz • México |
Publicación
Semanal
|
![]()
Regiones
Becas
y oportunidades
Arte
Deportes
Contraportada
|
Análisis
clínicos de CESS-UV están acreditados internacionalmente |
|
Instituciones
de Europa y Estados Unidos han avalado la calidad de los análisis
que realizan Los proyectos del centro son coordinados por académicos universitarios |
|
Veracruz,
Ver.- El Centro de Estudios y Servicios en Salud (CESS)
de la Universidad Veracruzana (UV) ha logrado acreditar 32 procesos
de análisis clínico a nivel internacional, destacó
Enrique González Deschamps, académico e investigador
de la institución. Como parte de una estrategia de internacionalización del CESS, agregó, se ha buscado obtener la aprobación de los procesos por parte de reconocidas instituciones a nivel internacional como el Centro de Control de Enfermedades y Prevención de Atlanta, Estados Unidos, y el Colegio de Patólogos de Londres, Inglaterra. Actualmente se trabaja en un proyecto internacional sobre la hipertensión arterial en una molécula: “Llamamos molécula a la investigación propia de un medicamento, ésta se realiza en Canadá, Estados Unidos y México, siendo aquí uno de los principales centros que se evalúan en el país.”, expresó González Deschamps. Todos los investigadores involucrados en este proyecto, además de los que participan en otros procesos cuyos estándares también se encuentran sometidos a evaluación, son académicos de la UV, precisó el investigador. Una de las formas de evaluación es el estudio denominado “Doble ciego”: un ensayo clínico controlado y aleatorio en donde ni el individuo ni los investigadores saben si el paciente está recibiendo el medicamento experimental o el placebo –explicó–, evitando así los sesgos de ambos en los resultados finales. Organizaciones latinoamericanas y estadounidenses, y actualmente el Colegio de Patólogos de Londres, han avalado ya varios de los análisis que realiza el CESS: “Ellos nos mandan muestras sin decir qué tienen; por ejemplo, envían muestras de glucosa que nosotros analizamos y ellos nos califican en un sistema internacional que tienen establecido”. La internacionalización del CESS es una estrategia que hemos concebido a largo plazo, puntualizó González Deschamps; para ello se requieren recursos y es precisamente donde nos encontramos ahora, buscando financiamiento orientado hacia la capacitación y mejora del equipo. Esta labor es un proceso que se construye por medio de la calidad en el trabajo del CESS, con la investigación se logra participar en la evaluación y al ser aprobados internacionalmente es posible obtener recursos que se invierten nuevamente en investigación, explicó el académico. |
|
|
